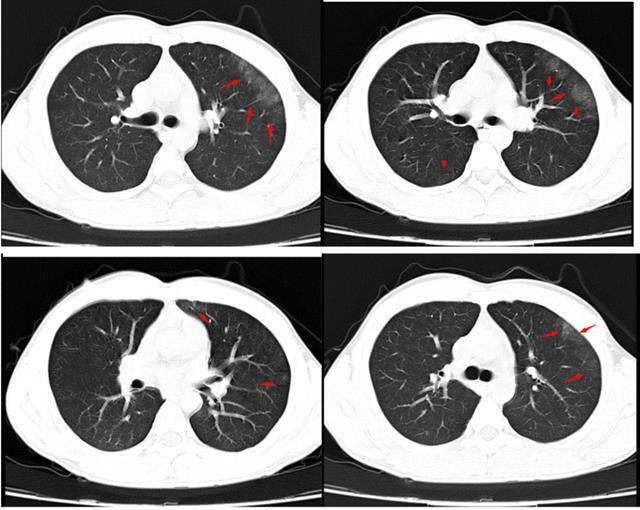
创伤性湿肺(肺挫伤)_肺部疾病_肺部疾病相关疾病 - 好大夫在线

肺挫伤

肺挫伤的影像诊断医学影像经典ppt
图片尺寸640x480
左肺严重挫伤
图片尺寸2667x2000
肺挫伤的影像诊断医学影像经典ppt
图片尺寸640x480
病例分享肺上叶挫伤│以影识病
图片尺寸480x480
肺挫裂伤和肺血肿
图片尺寸1080x810
有关肺挫伤的影像表现
图片尺寸1080x802
肺挫伤影像表现
图片尺寸1012x758
肺挫伤的影像诊断医学影像经典ppt
图片尺寸640x480
肺挫裂伤丨影像天地
图片尺寸600x600
肺挫伤的影像诊断医学影像经典ppt
图片尺寸640x480
肺挫伤
图片尺寸318x210
患者刘某,男,56岁,摔伤致左侧3~9肋骨骨折,左肺挫伤,左侧胸腔大量
图片尺寸2000x2667
创伤性湿肺(肺挫伤)_肺部疾病_肺部疾病相关疾病 - 好大夫在线
图片尺寸640x510
肺挫裂伤
图片尺寸1080x810
肺挫伤的影像诊断医学影像经典ppt
图片尺寸640x480
肺挫伤影像表现
图片尺寸965x758
有关肺挫伤的影像表现
图片尺寸1014x308
有关肺挫伤的影像表现
图片尺寸1017x270
命悬一线胸外科成功救治胸部贯通伤工人
图片尺寸422x544
肺挫伤的影像诊断医学影像经典ppt
图片尺寸640x480